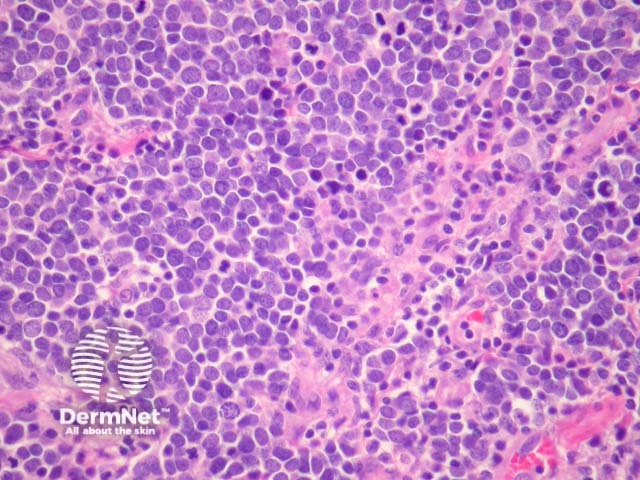
Figure 3

Main menu
Common skin conditions
NEWS
Join DermNet PRO
Read more
Quick links
Lesions (cancerous) Diagnosis and testing
Author: A/Prof Patrick Emanuel, Dermatopathologist, Auckland, New Zealand, 2013.
Merkel cell carcinoma is an aggressive tumour that usually arises on chronically sun exposed skin of the elderly. Ultraviolet radiation , immunosuppression and the Merkel cell polyomavirus (MCPyV) are thought to be causative factors. The cell of origin remains debatable but the immunohistochemical profile and morphology resemble native Merkel cells in the skin.
Merkel cell carcinoma is a neuroendocrine carcinoma composed of densely blue cells. The tumour is centered in the dermis with frequent involvement of the overlying epidermis (figures 1, 2) and may invade the subcutaneous fat. The tumour forms sheets, nests and rarely ribbons. The outlines of the cells often mold together or resemble lymphocytes (figures 3, 4). There are numerous mitoses, and there may be necrosis. Lymphovascular invasion is common.
Uncommonly, squamous or sarcomatoid differentiation may be seen in Merkel cell carcinoma. Actinic keratosis and in situ squamous cell carcinoma is commonly found in the overlying skin (figure 2). These findings have led some authors to believe Merkel cell carcinoma is a tumour derived from pleuripotent cells.

Figure 1

Figure 2
Figure 3

Figure 4

Figure 5
Immunohistochemical studies are essential. The tumour typically shows characteristic perinuclear staining with CK20 (figure 5). Other positive stains include CD56, chromogranin, synaptophysin, neurofilament.
Merkel cell carcinoma is negative for S100 and other melanoma markers.
p63 has emerged as an immunohistochemical stain which has been shown to provide some prognostic information. Strong diffuse staining is thought to be a negative prognostic feature.
Small cell carcinoma of the lung – These may be morphologically identical. Lung small cell carcinoma should be negative for CK20 and positive for TTF-1 (negative in Merkel cell carcinoma).
Basal cell carcinoma – As Merkel cell carcinoma may form islands of densely blue cells it may be misdiagnosed as a basal cell carcinoma. Close examination of the cells to reveal the high grade neuroendocrine differentiation and –if necessary- immunohistochemical studies may be useful in providing accurate distinction.
Melanoma – Immunohistochemical studies allow easy distinction.
Squamous cell carcinoma – Merkel cell carcinoma may show areas of squamous differentiation confusing. interpretation.